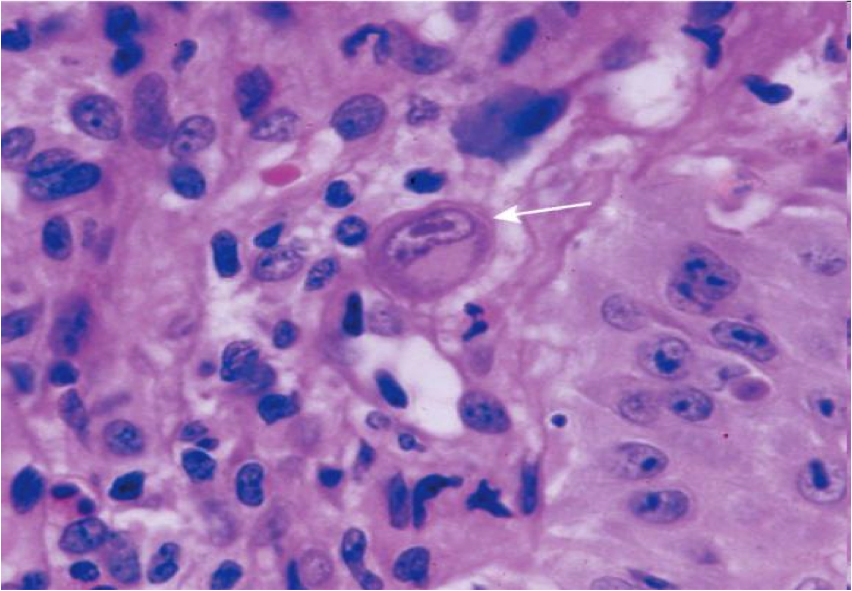

Histo of normal esophagus
esophageal atresia and tracheoesophageal fistula

Def: Embryologic failure of tubal esophagus to connect mouth to stomach, ending in a blind pouch; fistula may connect segment to trachea
Clinical:
abnormal hedgehog signaling

normal gastroesophageal junction
stratified sqaumous of esophagus
simple columnar of gastric cardia
esophageal ring

Concentric, thin diaphragm of tissue in the distal esophagus, most commonly at GE junction (Schatzki’s ring
esophageal webs

Esophageal diverticula

Outpouchings of the esophageal wall
Reflect underlying motor dysfunction
image=Zenker’s diverticulum

achalasia
def?
clinical?
microscopic?

Definition
Inability of the LES (lower esophageal sphincter) to relax after swallowing, resulting in periodic esophageal obstruction
Clinical
Dysphagia, odynophagia, regurgitation
inc. risk for squamous cell carcinoma
Microscopic Reduction or absence of myenteric ganglion cells

Symptoms: heartburn, acid regurg, dysphagia, globus sensation, chronic sore throat
Dx?
risk factors?
contributing factors?
Dx: GERD (Reflux of gastric acid into the esophagus with mucosal damage)
Risk Factors: Age, EtOH, tobacco (LES relaxation), chocolate
Contributing factors: hiatal hernia, weak LES, impaired esophageal peristalsis, delayed gastric emptying, inc gastric acid production

GERD
Hyperemia, vertical linear streaks represent superficial mucosal erosions/ulcers

GERD on bottom
squamous proliferation, papillae elongation, basal cell hyperplasia, inc. inflammation in lamina propria, decreased surface maturation
Note: biopsy findings are not specific! cannot make diagnosis w/ biopsy alone must have clinical info as well
Barrett’s esophagus
Def
Definition
Endoscopically recognizable columnar metaplasia of the esophageal mucosa that is confirmed pathologically to have intestinal metaplasia, the latter defined by goblet cells
Both the endoscopic and pathologic components should be present to establish BE.

Barrett’s esophagus: columnar metaplasia (intestinal metaplasia)+goblet cells

dysplasia in barrett’s
sequence of adenocarcinoma is metaplasia–>dysplasia–>carcinoma
Sx: dysphagia, food impaction
Hx: allergies, failed antireflux therapy
Tests: normal pH monitoring
Dx?

primary eosinophilic esophagitis (>15 eos/hpf from pts who lack a positive response to proton-pump inhibitors, have normal pH monitoring, or both)


herpes esophagitis
lateral margin of ulcer
cowdry A intranuclear inclusions (Multinucleation, chromatin Margination, nuclear Molding)
CMV esophagitis

Candida esophagitis

esophageal varices: Dilatation of submucosal esophageal veins
most often due to portal hypertension secondary to cirrhosis


Fundus, body
Parietal (oxyntic) glands
Pink = parietal cell
Blue/purple = chief cell

Cardia and Antrum
Cardiac/antral glands
Mucus cells
Congenital hypertrophic pyloric stenosis

-M:F 4:1
Mostly Caucasian; rare in blacks & Asians
-Possible genetic as well as environmental (drugs, infection in utero) pathogenesis
gastritis:
acute vs chronic vs reactive
Acute gastritis
Erosive/hemorrhagic
Chronic gastritis
Autoimmune
H. pylori associated
Lymphocytic (see text)
Granulomatous (see text)
Eosinophilic (see text)
Collagenous (see text)
Reactive gastropathy
Chemical (see text)
Sx: abrupt onset abdominal pain and bleeding
Hx: alchohol use, NSAIDS
Dx?
Most common etiology?
Path findings?
Therapy?

Dx: Acute erosive/hemorrhagic gastritis (stress gastritis) (Abrupt onset of ab pain & bleeding a/w ETOH, NSAIDs, or low hemodynamic state following trauma)
Due to Breakdown of mucosal barrier (Direct irritant action, Drug mechanism of action, Hypoperfusion)
Most common etiologies: NSAIDS, post-op state
Gross: Petechiae, erosions, ulcers
Microscopic: Limited to mucosa: superficial lamina propria hemorrhage, mucosal sloughing/necrosis, neutrophils
Therapy: Acid-supression (histamine blockers, proton-pump inhibitors)
